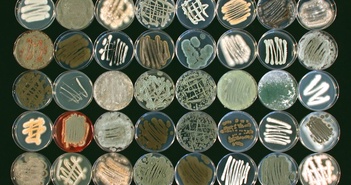

Tin tức về "đại dương"

Công trình nghiên cứu vừa được công bố trên tạp chí Science Advances mở ra khả năng chứng minh có si ...

Với công nghệ đẩy siêu êm và cách âm tiên tiến, cùng sonar mạnh và hỏa lực hiện đại, Astute tái định ...
Một nhóm nghiên cứu tại Đại học Hawaii (Mỹ) đang huấn luyện một loại nấm biển có khả năng phân hủy n ...

Theo nghiên cứu mới, mặc dù Sao Hỏa có thể cách Trái Đất đến khoảng 225 triệu km, nhưng hành tinh nà ...

Đại dương bên trong Mimas có thể chiếm hơn một nửa tổng thể tích của nó, nhưng chỉ bằng 1,2-1,4% tổn ...

Một trong những mặt trăng của Sao Thổ, có hình dáng tương tự như

Các nhà khoa học Mỹ gần như bị sốc khi phát hiện một cấu trúc chưa từng biết, lạ lùng, cổ xưa, bao q ...

Nhiệt độ đại dương đang tăng ở mức báo động

Nước bao phủ 70% bề mặt Trái đất, nhưng chưa đến 1% trong số đó có thể uống được.

Đây rất có thể là một sự kiện hi hữu bắt nguồn từ khao khát được làm mẹ của một con cá voi sát thủ c ...

Trái đất của chúng ta là một hành tinh vô cùng rộng lớn mà con người chưa thể chinh phục hoàn toàn. ...
